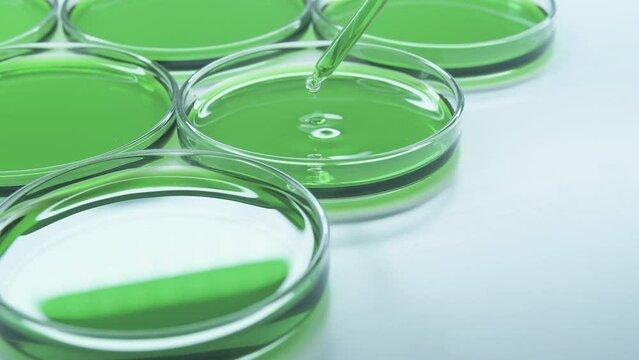

Patrocinado
Ngôn Ngữ Cá Cược ở Việt Nam: Hiểu Biết và Cách Sử Dụng
Cá cược không chỉ là một hoạt động giải trí mà còn có một hệ thống ngôn ngữ đặc biệt, phong phú và đầy sắc thái. Tại Việt Nam, việc tham gia cá cược, dù là cá cược thể thao, xổ số hay các trò chơi sòng bạc, đều đi kèm với một loạt thuật ngữ riêng biệt mà người tham gia cần nắm vững để hiểu và tham gia đúng cách. Bài viết này sẽ giới thiệu một số thuật ngữ quan trọng và thông dụng trong ngôn ngữ cá cược tại Việt Nam.
1. Các Thuật Ngữ Cơ Bản Trong Cá Cược link vào XX88
Cược (Bet): Là hành động đặt tiền vào một sự kiện hoặc kết quả với hy vọng thắng. Cược có thể được đặt trong nhiều loại hình như thể thao, xổ số hay trò chơi sòng bạc.
Kèo (Odds): Là tỷ lệ cược mà nhà cái đưa ra, phản ánh khả năng xảy ra của một sự kiện nào đó. Ví dụ, nếu tỷ lệ cược là 2.0, bạn sẽ nhận lại gấp đôi số tiền đã cược nếu thắng.
Cược Chấp (Handicap): Đây là một hình thức cá cược trong đó đội mạnh sẽ phải chấp đội yếu một số bàn thắng nhất định. Mục đích của cược chấp là tạo sự cân bằng giữa hai đội có chênh lệch sức mạnh rõ rệt.
Cược Dự Đoán (Prediction Bet): Là một loại cược trong đó người chơi dự đoán kết quả của một sự kiện, chẳng hạn như đội nào sẽ thắng, tỷ số ra sao hoặc số bàn thắng trong một trận đấu.
Tài xỉu (Over/Under): Là loại cược dựa trên tổng số điểm, số bàn thắng hoặc số lần ghi bàn trong một sự kiện thể thao. Người chơi cược vào việc tổng số sẽ cao hơn (tài) hay thấp hơn (xỉu) một mức nhất định mà nhà cái đưa ra.
2. Cá Cược Thể Thao: Những Thuật Ngữ Thường Gặp
Cá cược thể thao là một trong những hình thức cá cược phổ biến nhất ở Việt Nam, đặc biệt là cá cược bóng đá. Dưới đây là một số thuật ngữ thường gặp:
Kèo 1x2: Là loại cược phổ biến trong cá cược bóng đá, trong đó bạn chọn đội thắng, hòa, hoặc thua trong trận đấu.
Kèo Châu Á: Là loại cược mà nhà cái đưa ra một tỷ lệ cược với sự chấp (handicap) để tạo sự cân bằng giữa hai đội có sức mạnh khác nhau. Đội được chấp sẽ có một số bàn thắng cộng thêm vào kết quả.
Kèo Châu Âu: Đây là loại cược không có sự chấp, bạn chỉ cần chọn đội thắng, hòa hoặc thua trong trận đấu.
Kèo Tài Xỉu: Người chơi dự đoán tổng số bàn thắng trong một trận đấu sẽ cao hơn hay thấp hơn mức mà nhà cái đưa ra.
Cược Hiệp 1 / Hiệp 2: Đây là cược được đặt cho kết quả của từng hiệp đấu trong trận. Người chơi có thể chọn đội thắng trong hiệp 1, hiệp 2, hoặc kết quả tổng thể của cả hai hiệp.
3. Cá Cược Xổ Số và Các Thuật Ngữ Liên Quan
Cá cược xổ số tại Việt Nam cũng có một hệ thống thuật ngữ đặc biệt mà người chơi cần biết:
Xổ Số Kiến Thiết: Là loại hình xổ số do nhà nước tổ chức, với các giải thưởng lớn và nhỏ. Người chơi chọn số và chờ kết quả xổ số.
Vietlott: Là công ty xổ số điện toán quốc gia, với các loại hình xổ số như Mega 6/45, Power 6/55, và Max 4D. Người chơi chọn các bộ số và chờ kết quả.
Giải Đặc Biệt: Là giải thưởng lớn nhất trong xổ số, thường có giá trị cao và được trao cho những người trúng tất cả các con số.
4. Cá Cược Trực Tuyến: Thuật Ngữ Phổ Biến
Với sự phát triển của công nghệ, cá cược trực tuyến trở nên ngày càng phổ biến ở Việt Nam. Người tham gia cần hiểu một số thuật ngữ đặc trưng của cá cược trực tuyến:
Nhà Cái (Bookmaker): Là các tổ chức hoặc website cung cấp dịch vụ cá cược. Nhà cái đưa ra tỷ lệ cược và nhận cược từ người chơi.
Cược Trực Tuyến (Online Betting): Là hình thức cá cược được thực hiện qua các trang web hoặc ứng dụng điện thoại, thay vì trực tiếp tại các sòng bạc hoặc các cửa hàng cá cược.
Sòng Bạc Trực Tuyến (Online Casino): Là các nền tảng cá cược trực tuyến, nơi người chơi có thể tham gia các trò chơi sòng bạc như blackjack, poker, baccarat và các trò chơi khác.
5. Lưu Ý Khi Tham Gia Cá Cược
Chơi Có Trách Nhiệm: Việc hiểu và sử dụng đúng ngôn ngữ cá cược sẽ giúp người chơi tham gia một cách có trách nhiệm và kiểm soát được hành vi cá cược của mình.
Cẩn Thận Với Các Trang Web Không Chính Thức: Với cá cược trực tuyến, người chơi cần chọn những nhà cái uy tín và đảm bảo rằng họ đang tham gia vào một nền tảng hợp pháp.
Tìm Hiểu Luật Pháp: Mặc dù cá cược thể thao hoặc xổ số có thể hợp pháp tại Việt Nam trong một số hình thức, nhưng cá cược trực tuyến và các hình thức không được cấp phép có thể vi phạm pháp luật.
Kết Luận
Ngôn ngữ cá cược tại Việt Nam có sự phong phú và đa dạng, từ các thuật ngữ cơ bản đến các thuật ngữ đặc thù trong cá cược thể thao, xổ số, và cá cược trực tuyến. Việc hiểu rõ những thuật ngữ này sẽ giúp người chơi không chỉ tham gia một cách tự tin mà còn tránh được những sai sót không đáng có. Chơi cá cược cần có sự cân nhắc kỹ lưỡng và trách nhiệm để đảm bảo nó là một hoạt động giải trí lành mạnh và thú vị.
Categorias
Leia Mais
In the modern tech ecosystem, reliability and performance are critical. The Certified Site Reliability Engineer (SRE) Foundation certification from GSDC is designed for IT professionals aiming to enhance infrastructure stability, automate operations, and implement DevOps principles effectively. This foundational SRE certification provides deep insights into service-level objectives (SLOs),...

Physical and Chemical PropertiesFormic acid is a colorless liquid with a sharp, pungent odor similar to vinegar. Its chemical formula is HCOOH and it is the simplest carboxylic acid. At room temperature, formic acid is miscible with water and most organic solvents. It has a boiling point of 100.8°C and a melting point of 8.4°C. Formic acid is fairly stable but still reactive due to the...